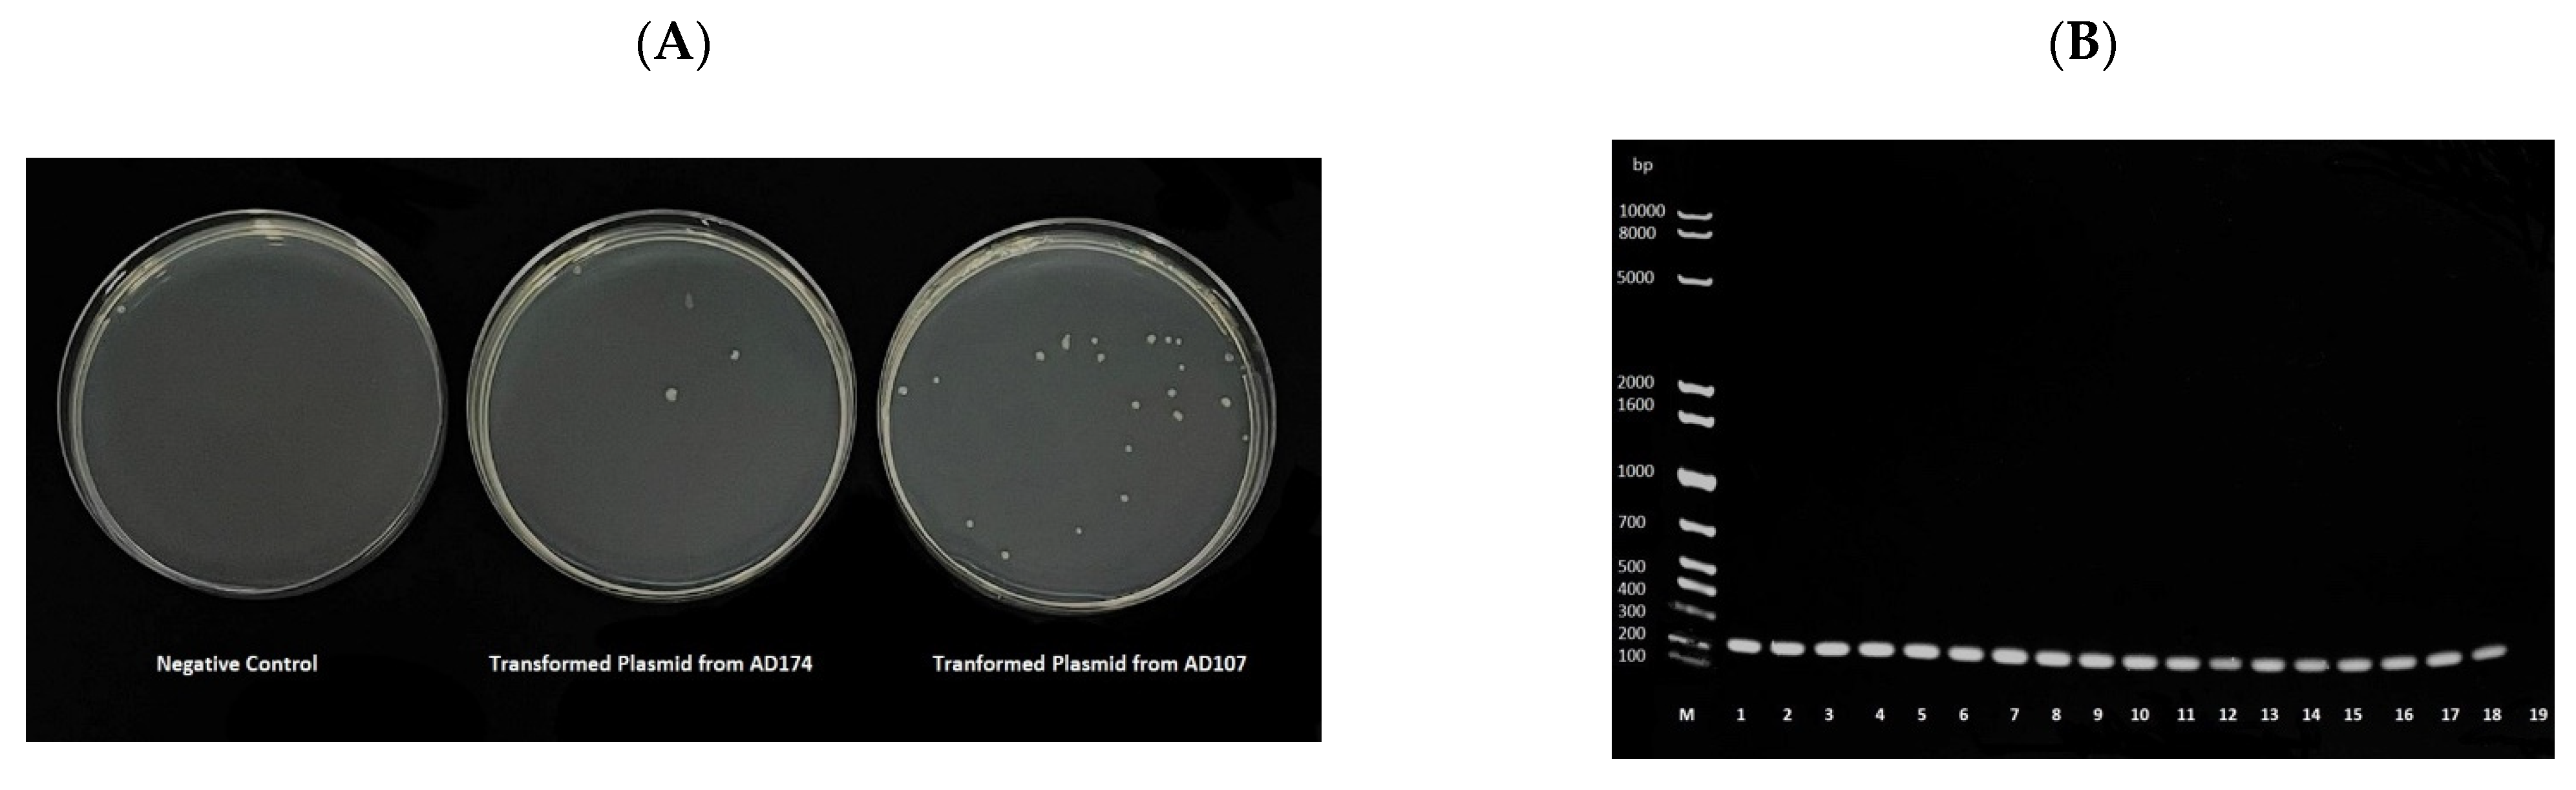
Antibiotics 11 00774 g002

Transmissibility and Persistence of the Plasmid-Borne Mobile Colistin Resistance Gene, mcr-1, Harbored in Poultry-Associated E. coli
Abstract
1. Introduction
2. Results
2.1. Antibiotic Susceptibility Profiles of the mcr-1-Carrying E.coli
2.2. Genomic Features and Diversity
2.3. Location of the mcr-1
2.4. Trasnmissibility of the mcr-1 via Conjugation
2.5. Presistence of the mcr-1 Plasmids in Biofilms
3. Discussion
4. Materials and Methods
4.1. Bacterial Isolates
4.2. Antimicrobial Susceptibility Testing
4.3. Whole-Genome Sequencing
4.4. Bioinformatics Analysis
4.5. Plasmid Extraction and Screening for mcr-1 Using PCR Analysis
4.6. Assessing mcr-1 Transmissibility Using the Heat Shock Method
4.7. Assessing mcr-1 Transmissibility via Conjugation Assays
4.8. Assessing the Persistence of mcr-1 Plasmids in Biofilms
4.9. Data Analysis
5. Conclusions
Supplementary Materials
Author Contributions
Funding
Institutional Review Board Statement
Informed Consent Statement
Data Availability Statement
Acknowledgments
Conflicts of Interest
References
- Ross, S.; Puig, J.R.; Zaremba, E.A. Colistin: Some preliminary laboratory and clinical observations in specific gastroenteritis in infants and children. Antibiot Annu. 1960, 7, 89–100. [Google Scholar]
- Akajagbor, D.S.; Wilson, S.L.; Shere-Wolfe, K.D.; Dakum, P.; Charurat, M.E.; Gilliam, B.L. Higher Incidence of Acute Kidney Injury With Intravenous Colistimethate Sodium Compared With Polymyxin B in Critically Ill Patients at a Tertiary Care Medical Center. Clin. Infect. Dis. 2013, 57, 1300–1303. [Google Scholar] [CrossRef] [PubMed]
- Falagas, M.E.; Kasiakou, S.K.; Saravolatz, L.D. Colistin: The Revival of Polymyxins for the Management of Multidrug-Resistant Gram-Negative Bacterial Infections. Clin. Infect. Dis. 2005, 40, 1333–1341. [Google Scholar] [CrossRef] [PubMed]
- Velkov, T.; Thompson, P.E.; Nation, R.L.; Li, J. Structure−Activity Relationships of Polymyxin Antibiotics. J. Med. Chem. 2009, 53, 1898–1916. [Google Scholar] [CrossRef] [PubMed]
- Biswas, S.; Brunel, J.-M.; Dubus, J.-C.; Reynaud-Gaubert, M.; Rolain, J.-M. Colistin: An update on the antibiotic of the 21st century. Expert Rev. Anti-Infect. Ther. 2012, 10, 917–934. [Google Scholar] [CrossRef] [PubMed]
- Olaitan, A.O.; Morand, S.; Rolain, J.M. Mechanisms of polymyxin resistance: Acquired and intrinsic resistance in bacteria. Front. Microbiol. 2014, 5, 643. [Google Scholar] [CrossRef] [PubMed]
- Liu, Y.Y.; Wang, Y.; Walsh, T.R.; Yi, L.X.; Zhang, R.; Spencer, J.; Doi, Y.; Tian, G.; Dong, B.; Huang, X.; et al. Emergence of plasmid-mediated colistin resistance mechanism MCR-1 in animals and human beings in China: A microbiological and molecular biological study. Lancet Infect. Dis. 2016, 16, 161–168. [Google Scholar] [CrossRef]
- Xavier, B.B.; Lammens, C.; Ruhal, R.; Kumar-Singh, S.; Butaye, P.; Goossens, H.; Malhotra-Kumar, S. Identification of a novel plasmid-mediated colistin-resistance gene, mcr-2, in Escherichia coli, Belgium, June 2016. Euro Surveill. Bull. Eur. Sur Mal. Transm. Eur. Commun. Dis. Bull. 2016, 7, 21. [Google Scholar] [CrossRef]
- Yin, W.; Li, H.; Shen, Y.; Liu, Z.; Wang, S.; Shen, Z.; Zhang, R.; Walsh, T.R.; Shen, J.; Wang, Y. Novel Plasmid-Mediated Colistin Resistance Gene mcr-3 in Escherichia coli. mBio 2017, 8, e00543-17. [Google Scholar] [CrossRef]
- Carattoli, A.; Villa, L.; Feudi, C.; Curcio, L.; Orsini, S.; Luppi, A.; Pezzotti, G.; Magistrali, C.F. Novel plasmid-mediated colistin resistance mcr-4 gene in Salmonella and Escherichia coli, Italy 2013, Spain and Belgium, 2015 to 2016. Eurosurveillance 2017, 22, 30589. [Google Scholar] [CrossRef]
- Borowiak, M.; Fischer, J.; Hammerl, J.A.; Hendriksen, R.S.; Szabo, I.; Malorny, B. Identification of a novel transposon-associated phosphoethanolamine transferase gene, mcr-5, conferring colistin resistance in d-tartrate fermenting Salmonella enterica subsp. enterica serovar Paratyphi B. J. Antimicrob. Chemother. 2017, 72, 3317–3324. [Google Scholar] [CrossRef] [PubMed]
- AbuOun, M.; Stubberfield, E.J.; Duggett, N.A.; Kirchner, M.; Dormer, L.; Nunez-Garcia, J.; Randall, L.P.; Lemma, F.; Crook, D.W.; Teale, C.; et al. mcr-1 and mcr-2 (mcr-6.1) variant genes identified in Moraxella species isolated from pigs in Great Britain from 2014 to 2015. J. Antimicrob. Chemother. 2018, 73, 2904. [Google Scholar] [CrossRef] [PubMed]
- Yang, Y.-Q.; Li, Y.-X.; Lei, C.-W.; Zhang, A.; Wang, H.-N. Novel plasmid-mediated colistin resistance gene mcr-7.1 in Klebsiella pneumoniae. J. Antimicrob. Chemother. 2018, 73, 1791–1795. [Google Scholar] [CrossRef] [PubMed]
- Wang, X.; Wang, Y.; Zhou, Y.; Li, J.; Yin, W.; Wang, S.; Zhang, S.; Shen, J.; Shen, Z.; Wang, Y. Emergence of a novel mobile colistin resistance gene, mcr-8, in NDM-producing Klebsiella pneumoniae. Emerg. Microbes Infect. 2018, 7, 122. [Google Scholar] [CrossRef]
- Carroll, L.M.; Gaballa, A.; Guldimann, C.; Sullivan, G.; Henderson, L.O.; Wiedmann, M. Identification of Novel Mobilized Colistin Resistance Gene mcr-9 in a Multidrug-Resistant, Colistin-Susceptible Salmonella enterica Serotype Typhimurium Isolate. mBio 2019, 10, e00853-19. [Google Scholar] [CrossRef]
- Wang, C.; Feng, Y.; Liu, L.; Wei, L.; Kang, M.; Zong, Z. Identification of novel mobile colistin resistance gene mcr-10. Emerg. Microbes Infect. 2020, 9, 508–516. [Google Scholar] [CrossRef]
- Khedher, M.B.; Baron, S.A.; Riziki, T.; Ruimy, R.; Raoult, D.; Diene, S.M.; Rolain, J.-M. Massive analysis of 64,628 bacterial genomes to decipher water reservoir and origin of mobile colistin resistance genes: Is there another role for these enzymes? Sci Rep. 2020, 10, 5970. [Google Scholar] [CrossRef]
- Feng, Y. Transferability of MCR-1/2 Polymyxin Resistance: Complex Dissemination and Genetic Mechanism. ACS Infect. Dis. 2018, 4, 291–300. [Google Scholar] [CrossRef]
- El-Sayed Ahmed, M.A.E.G.; Zhong, L.L.; Shen, C.; Yang, Y.; Doi, Y.; Tian, G.B. Colistin and its role in the Era of antibiotic resistance: An extended review (2000–2019). Emerg. Microbes Infect. 2020, 9, 868–885. [Google Scholar] [CrossRef]
- Poirel, L.; Jayol, A.; Nordmann, P. Polymyxins: Antibacterial Activity, Susceptibility Testing, and Resistance Mechanisms Encoded by Plasmids or Chromosomes. Clin. Microbiol. Rev. 2017, 30, 557–596. [Google Scholar] [CrossRef]
- Lima, T.; Domingues, S.; Da Silva, G.J. Plasmid-Mediated Colistin Resistance in Salmonella enterica: A Review. Microorganisms 2019, 7, 55. [Google Scholar] [CrossRef] [PubMed]
- Zhao, F.; Feng, Y.; Lü, X.; McNally, A.; Zong, Z. IncP Plasmid Carrying Colistin Resistance Gene mcr-1 in Klebsiella pneumoniae from Hospital Sewage. Antimicrob. Agents Chemother. 2017, 61, e02229-16. [Google Scholar] [CrossRef] [PubMed]
- Yang, R.S.; Feng, Y.; Lv, X.Y.; Duan, J.H.; Chen, J.; Fang, L.X.; Xia, J.; Liao, X.-P.; Sun, J.; Liu, Y.-H. Emergence of NDM-5- and MCR-1-Producing Escherichia coli Clones ST648 and ST156 from a Single Muscovy Duck (Cairina moschata). Antimicrob. Agents Chemother. 2016, 60, 6899–6902. [Google Scholar] [CrossRef] [PubMed]
- Gao, R.; Hu, Y.; Li, Z.; Sun, J.; Wang, Q.; Lin, J.; Ye, H.; Liu, F.; Srinivas, S.; Li, D.; et al. Dissemination and Mechanism for the MCR-1 Colistin Resistance. PLoS Pathog. 2016, 12, e1005957. [Google Scholar] [CrossRef]
- Matamoros, S.; van Hattem, J.M.; Arcilla, M.S.; Willemse, N.; Melles, D.C.; Penders, J.; Vinh, T.N.; Thi Hoa, N.; Bootsma, M.C.J.; van Genderen, P.J.; et al. Global phylogenetic analysis of Escherichia coli and plasmids carrying the mcr-1 gene indicates bacterial diversity but plasmid restriction. Sci Rep. 2017, 7, 15364. [Google Scholar] [CrossRef]
- Wang, Q.; Sun, J.; Li, J.; Ding, Y.; Li, X.P.; Lin, J.; Hassan, B.; Feng, Y. Expanding landscapes of the diversified mcr-1-bearing plasmid reservoirs. Microbiome 2017, 5, 70. [Google Scholar] [CrossRef]
- Rebelo, A.R.; Bortolaia, V.; Kjeldgaard, J.S.; Pedersen, S.K.; Leekitcharoenphon, P.; Hansen, I.M.; Guerra, B.; Malorny, B.; Borowiak, M.; Hammerl, J.A.; et al. Multiplex PCR for detection of plasmid-mediated colistin resistance determinants, mcr-1, mcr-2, mcr-3, mcr-4 and mcr-5 for surveillance purposes. Euro Surveill. Bull. Eur. Sur Mal. Transm. Eur. Commun. Dis. Bull. 2018, 23, 17-00672. [Google Scholar] [CrossRef]
- Eltai, N.O.; Yassine, H.M.; El-Obeid, T.; Al-Hadidi, S.H.; Al Thani, A.A.; Alali, W.Q. Prevalence of Antibiotic-Resistant Escherichia coli Isolates from Local and Imported Retail Chicken Carcasses. J Food Prot. 2020, 83, 2200–2208. [Google Scholar] [CrossRef]
- Johar, A.; Al-Thani, N.; Al-Hadidi, S.; Dlissi, E.; Mahmoud, M.; Eltai, N. Antibiotic Resistance and Virulence Gene Patterns Associated with Avian Pathogenic Escherichia coli (APEC) from Broiler Chickens in Qatar. Antibiotics 2021, 10, 564. [Google Scholar] [CrossRef]
- Magiorakos, A.P.; Srinivasan, A.; Carey, R.B.; Carmeli, Y.; Falagas, M.E.; Giske, C.G.; Harbarth, S.; Hindler, J.F.; Khalmeter, G.; Olsson-Lilijequist, B.; et al. Multidrug-resistant, extensively drug-resistant and pandrug-resistant bacteria: An international expert proposal for interim standard definitions for acquired resistance. Clin. Microbiol. Infect. 2012, 18, 268–281. [Google Scholar] [CrossRef]
- Arredondo-Alonso, S.; Rogers, M.R.C.; Braat, J.C.; Verschuuren, T.D.; Top, J.; Corander, J.; Willems, R.J.L.; Schürch, A.C.Y. mlplasmids: A user-friendly tool to predict plasmid- and chromosome-derived sequences for single species. Microb. Genom. 2018, 4, e000224. [Google Scholar] [CrossRef] [PubMed]
- Johansson, M.H.K.; Bortolaia, V.; Tansirichaiya, S.; Aarestrup, F.M.; Roberts, A.P.; Petersen, T.N. Detection of mobile genetic elements associated with antibiotic resistance in Salmonella enterica using a newly developed web tool: MobileElementFinder. J. Antimicrob. Chemother. 2020, 76, 101–109. [Google Scholar] [CrossRef] [PubMed]
- Elbediwi, M.; Li, Y.; Paudyal, N.; Pan, H.; Li, X.; Xie, S.; Rajkovic, A.; Feng, Y.; Fang, W.; Rankin, S.C.; et al. Global Burden of Colistin-Resistant Bacteria: Mobilized Colistin Resistance Genes Study (1980–2018). Microorganisms 2019, 7, 461. [Google Scholar] [CrossRef] [PubMed]
- Kawahara, R.; Fujiya, Y.; Yamaguchi, T.; Khong, D.T.; Nguyen, T.N.; Tran, H.T.; Yamamoto, Y. Most Domestic Livestock Possess Colistin-Resistant Commensal Escherichia coli Harboring mcr in a Rural Community in Vietnam. Antimicrob. Agents Chemother. 2019, 63, e00594-19. [Google Scholar] [CrossRef]
- Hmede, Z.; Kassem, I.I. The Colistin Resistance Gene mcr-1 Is Prevalent in Commensal Escherichia coli Isolated from Preharvest Poultry in Lebanon. Antimicrob. Agents Chemother. 2018, 62, e01304-18. [Google Scholar] [CrossRef]
- Rumi, M.V.; Mas, J.; Elena, A.; Cerdeira, L.; Muñoz, M.E.; Lincopan, N.; Gentilini, É.R.; Di Conza, J.; Gutkind, G. Co-occurrence of clinically relevant β-lactamases and MCR-1 encoding genes in Escherichia coli from companion animals in Argentina. Vet Microbiol. 2019, 230, 228–234. [Google Scholar] [CrossRef]
- Merida-Vieyra, J.; Ranero, A.D.C.; Arzate-Barbosa, P.; Garza EA de la Méndez-Tenorio, A.; Murcia-Garzón, J.; Aquino-Andrade, A. First clinical isolate of Escherichia coli harboring mcr-1 gene in Mexico. PLoS ONE 2019, 14, e0214648. [Google Scholar] [CrossRef]
- Eltai, N.O.; Abdfarag, E.A.; Al-Romaihi, H.; Wehedy, E.; Mahmoud, M.H.; Alawad, O.K.; Al-Hajri, M.M.; Al Thani, A.A.; Yassine, H.M. Antibiotic Resistance Profile of Commensal Escherichia coli Isolated from Broiler Chickens in Qatar. J. Food Prot. 2018, 81, 302–307. [Google Scholar] [CrossRef]
- McEwen, S.A.; Collignon, P.J. Antimicrobial Resistance: A One Health Perspective. Microbiol. Spectr. 2018, 6, 255–260. [Google Scholar] [CrossRef]
- Gordon, D.M.; Cowling, A. The distribution and genetic structure of Escherichia coli in Australian vertebrates: Host and geographic effects. Microbiology 2003, 149, 3575–3586. [Google Scholar] [CrossRef]
- Carlos, C.; Pires, M.M.; Stoppe, N.C.; Hachich, E.M.; Sato, M.I.; Gomes, T.A.; Amaral, L.A.; Ottoboni, L.M. Escherichia coli phylogenetic group determination and its application in the identification of the major animal source of fecal contamination. BMC Microbiol. 2010, 10, 161. [Google Scholar] [CrossRef] [PubMed]
- Fang, X.; Monk, J.M.; Mih, N.; Du, B.; Sastry, A.V.; Kavvas, E.; Seif, Y.; Smarr, L.; Palsson, B.O. Escherichia coli B2 strains prevalent in inflammatory bowel disease patients have distinct metabolic capabilities that enable colonization of intestinal mucosa. BMC Syst. Biol. 2018, 12, 66. [Google Scholar] [CrossRef] [PubMed]
- Fuentes-Castillo, D.; Esposito, F.; Cardoso, B.; Dalazen, G.; Moura, Q.; Fuga, B.; Fontana, H.; Cerdeira, L.; Dropa, M.; Rottmann, J.; et al. Genomic data reveal international lineages of critical priority Escherichia coli harbouring wide resistome in Andean condors (Vultur gryphus Linnaeus, 1758). Mol. Ecol. 2020, 29, 1919–1935. [Google Scholar] [CrossRef] [PubMed]
- Luo, Q.; Wang, Y.; Xiao, Y. Prevalence and transmission of mobilized colistin resistance (mcr) gene in bacteria common to animals and humans. Biosaf. Health 2020, 2, 71–78. [Google Scholar] [CrossRef]
- Kassem, I.I.; Mann, D.; Li, S.; Deng, X. Draft genome sequences and resistome analysis of multidrug-resistant mcr-1-harbouring Escherichia coli isolated from pre-harvest poultry in Lebanon. J. Glob. Antimicrob. Resist. 2021, 25, 114–116. [Google Scholar] [CrossRef] [PubMed]
- Hassan, J.; Eddine, R.Z.; Mann, D.; Li, S.; Deng, X.; Saoud, I.P.; Issmat, K.I. The Mobile Colistin Resistance Gene, mcr-1.1, Is Carried on IncX4 Plasmids in Multidrug Resistant E. coli Isolated from Rainbow Trout Aquaculture. Microorganisms 2020, 8, 1636. [Google Scholar] [CrossRef]
- Li, R.; Yu, H.; Xie, M.; Chen, K.; Dong, N.; Lin, D.; Chan, E.W.-C.; Chen, S. Genetic basis of chromosomally-encoded mcr-1 gene. Int. J. Antimicrob. Agents 2017, 51, 578–585. [Google Scholar] [CrossRef]
- Baur, B.; Hanselmann, K.; Schlimme, W.; Jenni, B. Genetic transformation in freshwater: Escherichia coli is able to develop natural competence. Appl. Environ. Microbiol. 1996, 62, 3673–3678. [Google Scholar] [CrossRef]
- Sinha, S.; Cameron, A.D.S.; Redfield, R.J. Sxy Induces a CRP-S Regulon in Escherichia coli. J. Bacteriol. 2009, 191, 5180–5195. [Google Scholar] [CrossRef]
- Sinha, S.; Redfield, R.J. Natural DNA Uptake by Escherichia coli. PLoS ONE 2012, 7, e35620. [Google Scholar] [CrossRef]
- Anjum, M.F.; Duggett, N.A.; AbuOun, M.; Randall, L.; Nunez-Garcia, J.; Ellis, R.J.; Rogers, J.; Horton, R.; Brena, C.; Williamson, S.; et al. Colistin resistance in Salmonella and Escherichia coli isolates from a pig farm in Great Britain. J. Antimicrob. Chemother. 2016, 71, 2306–2313. [Google Scholar] [CrossRef] [PubMed]
- Bowler, P.; Murphy, C.; Wolcott, R. Biofilm exacerbates antibiotic resistance: Is this a current oversight in antimicrobial stewardship? Antimicrob. Resist. Infect. Control. 2020, 9, 162. [Google Scholar] [CrossRef] [PubMed]
- Nang, S.C.; Morris, F.C.; McDonald, M.J.; Han, M.L.; Wang, J.; Strugnell, R.A.; Velkov, T.; Li, J. Fitness cost of mcr-1-mediated polymyxin resistance in Klebsiella pneumoniae. J. Antimicrob. Chemother. 2018, 73, 1604–1610. [Google Scholar] [CrossRef] [PubMed]
- CLSI. Performance Standards for Antimicrobial Susceptibility Testing (M100), 31st ed.; Clinical and Laboratory Standards Institute: Wayne, PA, USA, 2021. [Google Scholar]
- Wood, D.E.; Lu, J.; Langmead, B. Improved metagenomic analysis with Kraken 2. Genome Biol. 2019, 20, 257. [Google Scholar] [CrossRef]
- Bankevich, A.; Nurk, S.; Antipov, D.; Gurevich, A.A.; Dvorkin, M.; Kulikov, A.S.; Lesin, V.M.; Nikolenko, S.I.; Pham, S.; Prjibelski, A.D.; et al. SPAdes: A New Genome Assembly Algorithm and Its Applications to Single-Cell Sequencing. J. Comput. Biol. 2012, 19, 455–477. [Google Scholar] [CrossRef]
- Wick, R.R.; Judd, L.M.; Gorrie, C.L.; Holt, K.E. Unicycler: Resolving bacterial genome assemblies from short and long sequencing reads. PLoS Comput. Biol. 2016, 13, e1005595. [Google Scholar] [CrossRef]
- Price, M.N.; Dehal, P.S.; Arkin, A.P. FastTree: Computing Large Minimum Evolution Trees with Profiles instead of a Distance Matrix. Mol. Biol. Evol. 2009, 26, 1641–1650. [Google Scholar] [CrossRef]
- Price, M.N.; Dehal, P.S.; Arkin, A.P. FastTree 2–Approximately Maximum-Likelihood Trees for Large Alignments. PLoS ONE 2010, 5, e9490. [Google Scholar] [CrossRef]
- Beghain, J.; Bridier-Nahmias, A.; Le Nagard, H.; Denamur, E.; Clermont, O. ClermonTyping: An easy-to-use and accurate in silico method for Escherichia genus strain phylotyping. Microb. Genom. 2018, 4, e000192. [Google Scholar] [CrossRef]
- Inouye, M.; Dashnow, H.; Raven, L.; Schultz, M.B.; Pope, B.J.; Tomita, T.; Zobel, J.; Holt, K.E. SRST2: Rapid genomic surveillance for public health and hospital microbiology labs. bioRxiv 2014, 6, 90. [Google Scholar] [CrossRef]
- Carattoli, A.; Zankari, E.; García-Fernández, A.; Voldby Larsen, M.; Lund, O.; Villa, L.; Møller Aarestrup, F.; Hasman, H. In Silico Detection and Typing of Plasmids using PlasmidFinder and Plasmid Multilocus Sequence Typing. Antimicrob. Agents Chemother. 2014, 58, 3895–3903. [Google Scholar] [CrossRef] [PubMed]
- Joensen, K.G.; Scheutz, F.; Lund, O.; Hasman, H.; Kaas, R.S.; Nielsen, E.M.; Aarestrup, F.M. Real-time whole-genome sequencing for routine typing, surveillance, and outbreak detection of verotoxigenic Escherichia coli. J. Clin. Microbiol. 2014, 52, 1501–1510. [Google Scholar] [CrossRef] [PubMed]
- Roer, L.; Tchesnokova, V.; Allesøe, R.; Muradova, M.; Chattopadhyay, S.; Ahrenfeldt, J.; Thomsen, M.C.F.; Lund, O.; Hansen, F.; Hammerum, A.M.; et al. Development of a Web Tool for Escherichia coli Subtyping Based on fimH Alleles. J. Clin. Microbiol. 2017, 55, 2538–2543. [Google Scholar] [CrossRef]
- Wong, S.C.Y.; Tse, H.; Chen, J.H.K.; Cheng, V.C.C.; Ho, P.L.; Yuen, K.Y. Colistin-Resistant Enterobacteriaceae Carrying the mcr-1 Gene among Patients in Hong Kong. Emerg. Infect. Dis. 2016, 22, 1667–1669. [Google Scholar] [CrossRef] [PubMed]
- Froger, A.; Hall, J.E. Transformation of Plasmid DNA into E. coli Using the Heat Shock Method. J. Vis. Exp. 2007, 6, e253. [Google Scholar] [CrossRef]
- Hmede, Z.; Sulaiman, A.A.A.; Jaafar, H.; Kassem, I.I. Emergence of plasmid-borne colistin resistance gene mcr-1 in multidrug-resistant Escherichia coli isolated from irrigation water in Lebanon. Int. J. Antimicrob. Agents 2019, 54, 102–104. [Google Scholar] [CrossRef]
- R Core Team. R: A Language and Environment for Statistical Computing; R Foundation for Statistical Computing: Vienna, Austria, 2011; Available online: http://www.r-project.org/ (accessed on 24 February 2022).
- Wickham, H. ggplot2: Elegant Graphics for Data Analysis; Springer: Berlin/Heidelberg, Germany, 2016; Available online: https://ggplot2.tidyverse.org (accessed on 24 February 2022).
- Yu, G. Using ggtree to Visualize Data on Tree-Like Structures. Curr. Protoc. Bioinform. 2020, 69, e96. [Google Scholar] [CrossRef]
- Yu, G. Aplot: Decorate a “ggplot” with Associated Information. 2021. Available online: https://CRAN.R-project.org/package=aplot (accessed on 24 February 2022).

| Isolate | MIC (μg/mL) | Source | Phylogroup | Sequence Type | FimH Type | Plasmid Inc Types | Virulence Genes | Other Antibiotic Resistance Genes |
|---|---|---|---|---|---|---|---|---|
| ad107 | 8 | Retail chicken | B1 | 224 | fimH39 | IncFIA, IncFIB(APNANA1918), IncFII, IncFII(pCoo), IncI1, IncI2, IncX4 | cba, cma, etsC, gad, hlyF, iha, iroN, iss, iucC, iutA, lpfA, mchB, mchC, mchF, ompT, ompT, papC, sitA, terC, traT | aadA2_104, aph3″-Ib_146, aph6-Id.v2_172, AmpC1_286, cmlA1_2259, dfrA14.v1_2362, fosA4_1904, mphA_2174, mphB.v2_2176, strA.v1_2409, strB.v1_2410, sul3_2285, TEM-206_1678 |
| ad108 | 12 | Retail chicken | E | 1011 | fimH31 | Col(MG828), IncFII(pCoo), IncI1, IncI2, pNA111 | air, astA, chuA, eilA, hra, iss, terC, traT | aac3-IId_16, aadA8b_121, aph3″-Ib_146, aph3-Ia.v1_165, aph6-Id.v2_172, AmpC1_286, catA1_2229, dfrA15.v2_2365, erm42_2125, floR.v1_2271, fosA4_1904, mphA_2174, mphB.v2_2176, qnrS1_2006, strA.v1_2409, strB.v1_2410, sul3_2285, TEM-135.v2_1673, tetA.v1_2317 |
| ad174 | 8 | Retail chicken | A | 10 | fimH54 | Col(MG828), IncFIB(APNANA1918), IncFIC(FII), IncFII(pCoo), IncI2, pNA111 | cma, cvaC, gad, hlyF, iroN, iss, iucC, iutA, ompT, sitA, terC, traT | aadA8b_121, aph3″-Ib_146, aph3-Ia.v1_165, aph6-Id.v1_171, AmpC1_286, dfrA12_2360, fosA4_1904, mphA_2174, mphB.v2_2176, strA.v1_2409, strB.v1_2410, sul1_2283 |
| ad28 | 6 | Retail chicken | B1 | 6448 | fimH60 | Col(MG828), IncFIA, IncFIB(APNANA1918), IncFIC(FII), IncFII(pCoo), IncI1, IncI2 | cvaC, etsC, gad, hlyF, iroN, iss, iucC, iutA, mchF, ompT, sitA, terC, traT, tsh | erm42_2125, floR.v1_2271, fosA4_1904, mphA_2174, mphB.v2_2176, tetA.v1_2317 |
| ad80 | 12 | Retail chicken | A | 34 * | fimH24 | IncFIB(APNANA1918), IncFIC(FII), IncFII, IncI1, IncN, IncX1, IncX4 | etsC, gad, iss, terC, traT | aac3-IV_21, aadA24_108, aph3-Ia.v1_165, aph4-Ia_166, AmpC1_286, cmlA1_2259, floR.v1_2271, mefB_2098, mphA_2174, mphB.v2_2176, qnrB7_1992, sul3_2285, TEM-128.v2_1671 |
| ar181 | 8 | Retail chicken | B1 | 295 | fimH38 | Col(MG828), IncFIA, IncFIB(APNANA1918), IncFII(pCoo), IncHI2, IncHI2A, IncI1, IncI2 | astA, cea, cvaC, etsC, hlyF, iroN, iss, iucC, iutA, lpfA, lpfA, mchF, ompT, sitA, terC, traT, tsh | aadA15_101, AmpC1_286, dfrA1.v1_2357, fosA4_1904, mphA_2174, mphB.v2_2176, qnrB7_1992, sat-2_193, tetA.v1_2317 |
| ar182 | 8 | Retail chicken | A | NF | fimH54 | Col156, IncFIB(APNANA1918), IncFII, IncFII(29), IncHI2, IncHI2A, IncI1, IncN, pNA111 | celb, cma, cvaC, fyuA, gad, hlyF, iroN, irp2, iss, ompT, sitA, terC, traT | aadA24_108, aph3″-Ib_146, aph3-Ia.v1_165, aph6-Id.v1_171, AmpC1_286, cmlA1_2259, dfrA14.v1_2362, floR.v1_2271, mphA_2174, mphB.v2_2176, strA.v1_2409, strB.v1_2410, sul3_2285, TEM-207_1756, tetA.v1_2317 |
| br128 | 6 | Retail chicken | B1 | 155 | fimH121 | IncFIB(APNANA1918), IncHI2, IncHI2A, IncI2, IncQ1 | etsC, gad, hra, lpfA, terC | aac3-IIa.v1_12, aadA2_104, aph3″-Ib_146, aph3-Ia.v1_165, aph6-Id.v1_171, AmpC1_286, catA1_2229, cmlA1_2259, dfrA12_2360, floR.v1_2271, mphA_2174, mphB.v2_2176, strA.v1_2409, strB.v1_2410, sul3_2285, TEM-207_1756, tetA.v1_2317 |
| br129 | 6 | Retail chicken | A | 744 | fimH54 | Col(MG828), IncFIB(APNANA1918), IncFIC(FII), IncQ1, IncX1, IncX4, pNA111 | cba, cia, cma, cvaC, etsC, fyuA, gad, hlyF, iroN, irp2, iss, iucC, iutA, mchF, ompT, sitA, terC, traT, tsh | aadA5_114, aph3″-Ib_146, aph3-Ia.v1_165, aph6-Id.v1_171, AmpC1_286, catA1_2229, dfrA17_2369, floR.v1_2271, mphA_2174, mphB.v2_2176, strA.v1_2409, strB.v1_2410, sul1_2283, TEM-206_1678, tetB.v2_2325 |
| cd62 | 12 | Retail chicken | B1 | 295 | fimH38 | Col(MG828), IncFIA, IncFIB(APNANA1918), IncFII(pCoo), IncI1, IncI2 | astA, cea, cvaC, etsC, hlyF, iroN, iss, iucC, iutA, lpfA, lpfA, mchF, ompT, sitA, terC, traT, tsh | aadA12_98, AmpC1_286, dfrA1.v1_2357, fosA4_1904, mphA_2174, mphB.v2_2176, sat-2_193 |
| cd63 | 6 | Retail chicken | A | 48 | fimH54 | IncFIB(APNANA1918), IncFII, IncFII(pCoo), IncI1, IncI2, pNA111 | astA, gad, hlyF, iroN, iss, ompT, sitA, terC, traT | aadA2_104, aph3″-Ib_146, aph3-Ia.v1_165, aph6-Id.v2_172, AmpC1_286, cmlA1_2259, dfrA14.v1_2362, erm42_2125, floR.v1_2271, fosA4_1904, mphA_2174, mphB.v2_2176, strA.v1_2409, strB.v1_2410, sul3_2285, TEM-206_1678, tetA.v1_2317 |
| cr102 | 8 | Retail chicken | A | 48 | fimH41 | Col(MG828), IncFIB(K), IncFII(pCoo), IncFII(pSE11), IncI1, IncI2, IncX1, IncX4, pNA111 | astA, gad, terC, traT | aadA_93, aph3-Ia.v1_165, AmpC1_286, dfrA1.v1_2357, erm42_2125, floR.v1_2271, fosA4_1904, mphA_2174, mphB.v2_2176, sat-2_193, sul3_2285, TEM-176_1646, tetA.v1_2317 |
| cr103 | 8 | Retail chicken | A | 3270 | fimH31-like | Col(MG828), IncB/O/K/Z, IncFIB(APNANA1918), IncFII, IncFII(pCoo), IncI2 | cba, cea, cia, cma, cvaC, etsC, gad, hlyF, hra, iha, iroN, iss, iutA, kpsE, kpsMIII_K96, mchF, ompT, sitA, terC, traT | AmpC1_286, dfrA5_2387, fosA4_1904, mphA_2174, mphB.v2_2176, tetA.v1_2317 |
| FC1 | 3 | Fecal | B1 | 602 | fimH86 | IncFIB(APNANA1918), IncFII, IncI1, IncI2 | cia, cvaC, etsC, gad, hlyF, iroN, iss, iucC, iutA, lpfA, mchF, ompT, papC, sitA, terC, traT | aadA_93, aph3″-Ib_146, aph6-Id.v2_172, AmpC1_286, dfrA1.v1_2357, mphB.v2_2176, sat-2_193, strA.v1_2409, strB.v1_2410, sul2_2284, TEM-206_1678, tetB.v2_2325 |
| FC12 | 3 | Fecal | B1 | 602 | fimH86 | IncFIB(APNANA1918), IncFII, IncI1, IncI2 | cia, cvaC, etsC, gad, hlyF, iroN, iss, iucC, iutA, lpfA, mchF, ompT, papC, sitA, terC, traT | aadA_93, aph3″-Ib_146, aph6-Id.v2_172, AmpC1_286, dfrA1.v1_2357, mphB.v2_2176, sat-2_193, strA.v1_2409, strB.v1_2410, sul2_2284, TEM-206_1678, tetB.v2_2325 |
| FC4 | 3 | Fecal | B1 | 602 | fimH86 | IncFIB(APNANA1918), IncFII, IncI1, IncI2 | cia, cvaC, etsC, gad, hlyF, iroN, iss, iucC, iutA, lpfA, mchF, ompT, papC, sitA, terC, traT | aadA_93, aph3″-Ib_146, aph6-Id.v2_172, AmpC1_286, dfrA1.v1_2357, mphB.v2_2176, sat-2_193, strA.v1_2409, strB.v1_2410, sul2_2284, TEM-207_1756, tetB.v2_2325 |
| FC6 | 3 | Fecal | B2 | 355 | fimH154 | Col(MG828), IncFIB(APNANA1918), IncFIC(FII), IncI2 | cba, cea, chuA, cia, cma, fyuA, hlyF, hra, ibeA, irp2, iss, iucC, kpsE, kpsMII_K1, neuC, ompT, sitA, terC, traT, usp, vat, yfcV | - |
| FC7 | 3 | Fecal | B1 | 602 | fimH86 | IncFIB(APNANA1918), IncFIIIncI1, IncI2 | cia, cvaC, etsC, gad, hlyF, iroN, iss, iucC, iutA, lpfA, mchF, ompT, ompT, papC, sitA, terC, traT | aadA_93, aph3″-Ib_146, aph6-Id.v2_172, AmpC1_286, dfrA1.v1_2357, mphB.v2_2176, sat-2_193, strA.v1_2409, strB.v1_2410, sul2_2284, TEM-76_1698, tetB.v2_2325 |
| Isolate | Mlplasmids * Probability | MGEfinder * Result |
|---|---|---|
| ad107 | 0.34 | chromosome |
| ad108 | 0.76 | Incl2 |
| ad174 | 0.76 | Incl2 |
| ad28 | 0.79 | Incl2 |
| ad80 | 0.79 | IncX4 |
| ar181 | 0.62 | chromosome |
| ar182 | 0.39 | chromosome |
| br128 | 0.13 | chromosome |
| br129 | 0.78 | IncX4 |
| cd62 | 0.63 | chromosome |
| cd63 | 0.71 | Incl2 |
| cr102 | 0.81 | chromosome |
| cr103 | 0.77 | Incl2 |
| FC1 | 0.76 | Incl2 |
| FC12 | 0.75 | Incl2 |
| FC4 | 0.76 | Incl2 |
| FC6 | 0.76 | Incl2 |
| FC7 | 0.76 | Incl2 |
Publisher’s Note: MDPI stays neutral with regard to jurisdictional claims in published maps and institutional affiliations. |
© 2022 by the authors. Licensee MDPI, Basel, Switzerland. This article is an open access article distributed under the terms and conditions of the Creative Commons Attribution (CC BY) license (https://creativecommons.org/licenses/by/4.0/).
Share and Cite
Al Mana, H.; Johar, A.A.; Kassem, I.I.; Eltai, N.O. Transmissibility and Persistence of the Plasmid-Borne Mobile Colistin Resistance Gene, mcr-1, Harbored in Poultry-Associated E. coli. Antibiotics 2022, 11, 774. https://doi.org/10.3390/antibiotics11060774
Al Mana H, Johar AA, Kassem II, Eltai NO. Transmissibility and Persistence of the Plasmid-Borne Mobile Colistin Resistance Gene, mcr-1, Harbored in Poultry-Associated E. coli. Antibiotics. 2022; 11(6):774. https://doi.org/10.3390/antibiotics11060774
Chicago/Turabian StyleAl Mana, Hassan, Alreem A. Johar, Issmat I. Kassem, and Nahla O. Eltai. 2022. "Transmissibility and Persistence of the Plasmid-Borne Mobile Colistin Resistance Gene, mcr-1, Harbored in Poultry-Associated E. coli" Antibiotics 11, no. 6: 774. https://doi.org/10.3390/antibiotics11060774
APA StyleAl Mana, H., Johar, A. A., Kassem, I. I., & Eltai, N. O. (2022). Transmissibility and Persistence of the Plasmid-Borne Mobile Colistin Resistance Gene, mcr-1, Harbored in Poultry-Associated E. coli. Antibiotics, 11(6), 774. https://doi.org/10.3390/antibiotics11060774







